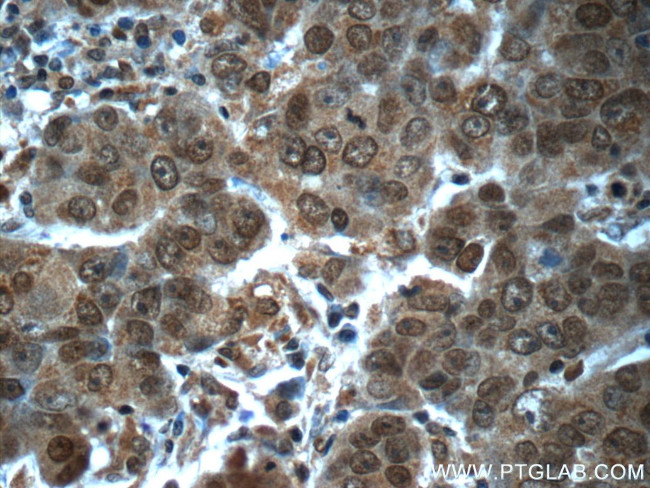
POTEA Antibody in Immunohistochemistry (Paraffin) (IHC (P))

Search
Proteintech
POTEA Polyclonal Antibody
{{$productOrderCtrl.translations['antibody.pdp.commerceCard.promotion.promotions']}}
{{$productOrderCtrl.translations['antibody.pdp.commerceCard.promotion.viewpromo']}}
{{$productOrderCtrl.translations['antibody.pdp.commerceCard.promotion.promocode']}}: {{promo.promoCode}} {{promo.promoTitle}} {{promo.promoDescription}}. {{$productOrderCtrl.translations['antibody.pdp.commerceCard.promotion.learnmore']}}
产品信息
24593-1-AP
种属反应
宿主/亚型
分类
类型
抗原
偶联物
形式
浓度
规格
纯化类型
保存液
内含物
保存条件
运输条件
产品详细信息
Immunogen sequence: IHSVDNLDD ITWPSEIASE DYDLLFSNYE TFTLLIEQLK MDFNDSASLS KIQDAVISEE HLLELKNSHY EQLTVEVEQM ENMVHVLQK (411-498 aa encoded by BC153076)
靶标信息
POTE8 (Prostate, ovary, testis-expressed protein on chromosome 8), also known as A26A1 (ANKRD26-like family A member 1) or POTEA (POTE ankyrin domain family, member A), is a 498 amino acid protein that contains five ANK repeats and is thought to participate in signaling events during reproductive development. POTE8 exists as two alternatively spliced isoforms which are encoded by a gene that maps to human chromosome 8. Consisting of nearly 146 million base pairs, chromosome 8 encodes over 800 genes and is associated with a variety of diseases and malignancies. Schizophrenia, bipolar disorder, Trisomy 8, Pfeiffer syndrome, congenital hypothyroidism, Waardenburg syndrome and some leukemias and lymphomas are thought to occur as a result of defects in specific genes that maps to chromosome 8.
仅用于科研。不用于诊断过程。未经明确授权不得转售。
篇参考文献 (0)
生物信息学
蛋白别名: ANKRD26-like family A member 1; ANKRD26-like family A, member 1; cancer/testis antigen family 104, member 3; POTE ankyrin domain family member A; POTE ankyrin domain family, member A; POTE-8; Prostate, ovary, testis-expressed protein on chromosome 8; protein expressed in prostate, ovary, testis, and placenta 8
基因别名: A26A1; CT104.3; POTE-8; POTE8; POTEA
UniProt ID: (Human) Q6S8J7
Entrez Gene ID: (Human) 340441